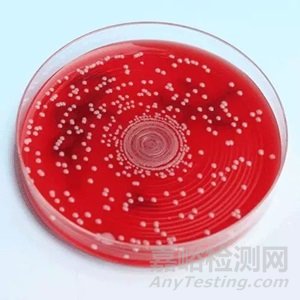

您當(dāng)前的位置:檢測(cè)資訊 > 實(shí)驗(yàn)管理
嘉峪檢測(cè)網(wǎng) 2024-05-27 08:47
為了微生物檢驗(yàn)的順利開展,最大限度地避免雜菌污染,需要我們熟練并規(guī)范地進(jìn)行無菌操作,無菌操作是試驗(yàn)成功的關(guān)鍵,必須嚴(yán)格遵守操作規(guī)程,以確保實(shí)驗(yàn)的順利進(jìn)行。
1、定義
是指在執(zhí)行實(shí)驗(yàn)過程中,防止一切微生物侵入機(jī)體和保持無菌物品及無菌區(qū)域不被污染的操作技術(shù)和管理方法;
無菌操作技術(shù)是微生物實(shí)驗(yàn)的基本技術(shù),是保證微生物實(shí)驗(yàn)準(zhǔn)確和順利完成的重要環(huán)節(jié)。
2、內(nèi)容
無菌操作技術(shù)主要包括兩方面:
1)創(chuàng)造無菌的培養(yǎng)環(huán)境。包括提供密閉的培養(yǎng)容器、培養(yǎng)容器的滅菌、培養(yǎng)基的滅菌等;
2)在操作和培養(yǎng)過程中防止一切其它微生物的侵入的措施。包括紫外線殺菌、甲醛熏蒸、超凈臺(tái)的消毒與檢測(cè)、操作工具、器皿滅菌、操作方法等。
3、無菌操作原則
1)在執(zhí)行無菌操作時(shí),必須明確物品的無菌區(qū)和非無菌區(qū),接種時(shí)必須穿工作服、戴工作帽應(yīng)在進(jìn)無菌室前用肥皂洗手,然后用75%酒精棉球?qū)⑹植粮蓛簦?/span>
2)在操作前20~30分鐘要先啟動(dòng)超凈臺(tái)和紫外燈,進(jìn)行接種所用的吸管、平皿及培養(yǎng)基等必須經(jīng)消毒滅菌,打開包裝未使用完的器皿,不能放置后再使用,金屬用具應(yīng)高壓滅菌或用95%酒精點(diǎn)燃燒灼3次后使用。嚴(yán)禁用手直接拿無菌物品,如瓶塞等,而必須用消毒的鉗、鑷子等;
3)從包裝中取出吸管時(shí),吸管尖部不能觸及外露部位,使用吸管接種于試管或平皿時(shí),吸管尖不能觸及試管或平皿邊;
4)接種樣品、轉(zhuǎn)種細(xì)菌必須在酒精燈前操作,接種細(xì)菌或樣品時(shí),吸管從包裝中取出后及打開試管塞都要通過火焰消毒;
5)接種環(huán)或接種針在接種細(xì)菌前應(yīng)經(jīng)火焰燒灼全部金屬絲,必須時(shí)還要燒到環(huán)和針與桿的連接處;
6)吸管吸取菌液或樣品時(shí),應(yīng)用相應(yīng)的橡皮頭吸取,不得直接用口吸。傾倒平板應(yīng)在超凈臺(tái)內(nèi)操作,并且在開啟和加蓋瓶塞時(shí)需反復(fù)用酒精燈燒。
二、無菌操作的環(huán)境要求
1、無菌室
(1)無菌室的結(jié)構(gòu):更衣間、緩沖間、操作間;
(2)無菌室的消毒和防污染
每日(使用前)紫外線照射(0.5~1小時(shí));
每月用新潔爾滅擦拭地面和墻壁一次的方式進(jìn)行消毒;
每季度用甲醛、乳酸、過氧乙酸熏蒸(2小時(shí)),特殊情況下可增加熏蒸頻次。
(3)無菌室使用要求
①無菌室內(nèi)應(yīng)保持清潔,工作后用2%-3%煤酚皂溶液消毒,拭擦工作臺(tái)面,不得存放與實(shí)驗(yàn)無關(guān)的物品;
②無菌室使用前后應(yīng)將門關(guān)緊,打開紫外線,如采用室內(nèi)懸吊紫外燈消毒時(shí),需30W紫外燈,距離在1.0m處,照射時(shí)間不少于30min,使用紫外燈,應(yīng)注意不得直接在紫外線下操作,以免引起損傷,燈管每隔兩周需用酒精棉球輕輕拭擦,除去上面灰塵和油垢,以減少紫外線穿透的影響;
③處理和接種食品標(biāo)本時(shí),進(jìn)入無菌室操作,不得隨意出入,如需要傳遞物品,可通過小窗傳遞。在無菌室內(nèi)如需要安裝空調(diào)時(shí),則應(yīng)有過濾裝置。
2、超凈工作臺(tái)
超凈臺(tái)的使用與保養(yǎng):
(1)風(fēng)速穩(wěn)定,且符合要求;
(2)使用前開啟紫外燈照射30分鐘以上;
(3)讓超凈臺(tái)預(yù)工作10-15分鐘;
(4)使用完畢后,用70%酒精將臺(tái)面和臺(tái)內(nèi)四周擦拭干凈。
3、無菌器材
(1)滅菌器材:玻璃器皿、培養(yǎng)基、無菌衣等;
(2)消毒器材:無菌室內(nèi)的凳子、試管架、天平、工作臺(tái)、手等。
(3)無菌間一般只允許放置無菌操作臺(tái)、轉(zhuǎn)椅等物品;無菌操作臺(tái)上一般只允許擺放以下物品: 酒精燈、打火機(jī)、接種針、消毒棉球、洗耳球、鑷子、油性筆、滅菌平皿、試管架、滅菌吸管、電子天平、250ml滅菌三角瓶、培養(yǎng)基、均質(zhì)器等。
三、無菌操作的基本技術(shù)
1、無菌接種操作
培養(yǎng)基經(jīng)高壓滅菌后,用經(jīng)過滅菌的工具(如接種針和吸管等)在無菌條件下接種含菌材料(如樣品、菌苔或菌懸液等)于培養(yǎng)基上,這個(gè)過程叫做無菌接種操作。
在實(shí)驗(yàn)室檢驗(yàn)中的各種接種必須是無菌操作。

1. 接種針灼燒滅菌
進(jìn)入超凈工作臺(tái)前,用75%酒精擦拭雙手,進(jìn)入超凈工作臺(tái)內(nèi),待酒精揮發(fā)完全,點(diǎn)燃酒精燈,將接種環(huán)及金屬棒在火焰上灼燒,將接種環(huán)燒至發(fā)紅,來回灼燒金屬棒,尤其是接口處。
2. 接種針冷卻
接種針滅菌后,移到酒精燈旁邊冷卻,備用。
3. 接種針接種
配制好固體或液體培養(yǎng)基后,利用高壓蒸汽滅菌鍋進(jìn)行滅菌,經(jīng)過滅菌后培養(yǎng)基里無任何微生物,在超過經(jīng)工作臺(tái)內(nèi),用接種針等將目標(biāo)菌種接種到培養(yǎng)基中的過程。
劃線分離:
由接種環(huán)沾取少許待分離的材料,在無菌平板表面進(jìn)行平行劃線、扇形劃線或其他形式的連續(xù)劃線,微生物細(xì)胞數(shù)量將隨著劃線次數(shù)的增加而減少,并逐步分散開來,如果劃線適宜的話,微生物能一一分散,經(jīng)培養(yǎng)后,可在平板表面得到單菌落。
①取菌種:取出目標(biāo)菌種,融化后,備用;
②接種針滅菌:灼燒接種針進(jìn)行滅菌;
③接種針冷卻:將接種針移至酒精燈旁邊冷卻;
④蘸取菌種:甘油管用75%酒精消毒,待酒精揮發(fā)完全,在酒精燈火焰略微滅菌(防止烤糊),然后用接種環(huán)蘸取一環(huán)菌種;
⑤劃線:取已經(jīng)備好的固體平板,邊轉(zhuǎn)動(dòng)平板邊用酒精燈火焰滅菌,打開平板(靠口朝酒精燈),用上述接種環(huán)在平板上劃線,先在一側(cè)連續(xù)劃線3-4次,邊轉(zhuǎn)動(dòng)平板邊用酒精燈灼燒接種環(huán),冷卻后,用接種環(huán)穿過第一次劃線部分繼續(xù)劃線3-4次,同樣方法進(jìn)行第三次劃線,或第四次劃線(根據(jù)菌液濃度和菌種類型確定劃線次數(shù)),灼燒接種環(huán);
⑥標(biāo)記:在平板底部邊緣處標(biāo)記菌種名稱,日期和其他信息;
⑦培養(yǎng):放置于恒溫培養(yǎng)箱中培養(yǎng);
⑧保存:待培養(yǎng)完成后保存于4℃冰箱,待用。
涂布法接種:
先將培養(yǎng)基熔化后趁熱倒入無菌平板中,然后用無菌吸管吸取0.1ml 菌液接種在已凝固的瓊脂平板上。再用無菌L 型玻璃棒將菌液在平板上涂抹均勻,將涂抹好的平板平放于桌上20~30min,使菌液滲透入培養(yǎng)基內(nèi),然后將平板倒轉(zhuǎn),保溫培養(yǎng),至長(zhǎng)出菌落后即可計(jì)數(shù)。
斜面接種:
從生長(zhǎng)好的平板菌種轉(zhuǎn)接到新鮮斜面培養(yǎng)基上的接種。主要用于接種純菌,使其增殖后用以鑒定或保存菌種。

①取菌種:取出目標(biāo)菌種平板;
②接種針滅菌:灼燒接種針進(jìn)行滅菌;
③接種針冷卻:將接種針移至酒精燈旁邊冷卻;
④挑取菌種:在火焰旁打開平板塞子,邊轉(zhuǎn)動(dòng)平板邊用酒精燈火焰滅菌,打開平板(靠口朝酒精燈),立即將接種環(huán)伸入平板上,挑取單菌落后蓋上平板蓋子,然后左手迅速取出新鮮試管,在火焰旁右手小指取下塞子,并灼燒試管管口,將黏有單菌落的接種環(huán)迅速放進(jìn)新鮮斜面的底部,從下至上Z字劃線,蓋上試管塞,灼燒接種環(huán);
⑤標(biāo)記:在平板底部邊緣處標(biāo)記菌種名稱,日期和其他信息;
⑥培養(yǎng):放置于恒溫培養(yǎng)箱中培養(yǎng);
⑦保存:待培養(yǎng)完成后保存于4℃冰箱,待用。
液體接種:
將接種環(huán)送入液體培養(yǎng)基時(shí)使環(huán)在液體與管壁接觸的地方輕輕磨擦,使菌體分散,塞上試管塞再輕輕搖勻。
多用于增菌液進(jìn)行增菌培養(yǎng),也可用純培養(yǎng)菌接種液體培養(yǎng)基進(jìn)行生化試驗(yàn),其操作方法與注意事項(xiàng)與斜面接種法基本相同。
傾倒法接種:
吸取1ml 菌液加入平板中,倒入已融化并冷卻至45~50℃的細(xì)菌培養(yǎng)基,輕輕轉(zhuǎn)動(dòng)平板,使菌液與培養(yǎng)基混合均勻,冷疑后倒置,適溫培養(yǎng)。至長(zhǎng)出菌落后即可計(jì)數(shù)。

螺旋接種法:
可以在無任何全部或中間稀釋的情況下快速細(xì)菌接種。對(duì)數(shù)減少的樣品容量以阿基米德螺旋線的形式被自動(dòng)分注在旋轉(zhuǎn)式培養(yǎng)基表面。培養(yǎng)基上每一點(diǎn)的容量可以被知曉和校準(zhǔn)。菌液的濃度可以通過培養(yǎng)皿上一定區(qū)域的菌落數(shù)量除以同區(qū)域樣品分注量來計(jì)算。
四、微生物檢驗(yàn)過程中的注意事項(xiàng)
(1)在操作中不應(yīng)有大幅度或快速的動(dòng)作;
(2)使用玻璃器皿應(yīng)輕取輕放;
(3)在正火焰上方操作;
(4)接種用具在使用前、后都必須灼燒滅菌;
(5)在接種培養(yǎng)物時(shí),協(xié)作應(yīng)輕、準(zhǔn);
(6)不能用嘴直接吸吹吸管;
(7)帶有菌液的吸管、玻片等器材應(yīng)及時(shí)置于盛有5%來蘇爾溶液的消毒桶內(nèi)消毒。
文章來源:《食品微生物檢測(cè)實(shí)驗(yàn)技術(shù)》周紅麗等主編 中國(guó)標(biāo)準(zhǔn)出版社出版;

來源:Internet